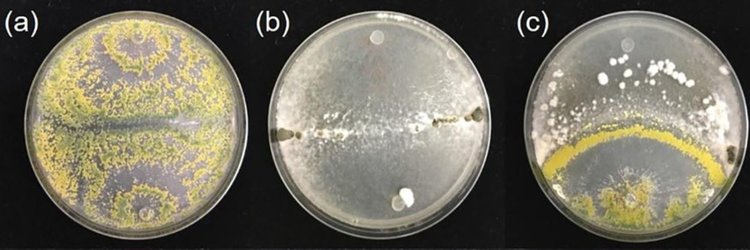

Учёные из Ротамстеда совместно с партнёрами из университетов Уорика и Эксетера обнаружили, что гриб Trichoderma hamatum, известный своими защитными свойствами для растений, выделяет летучие органические соединения (ЛОС), которые подавляют рост патогенов сельскохозяйственных культур.
В лабораторных испытаниях эти естественные испарения остановили распространение Sclerotinia sclerotiorum – плесени, вызывающей гниение таких культур, как салат, фасоль и рапс.
Это открытие вселяет новую надежду на более экологичную защиту растений в то время, когда сельское хозяйство находится под давлением необходимости сокращать использование химикатов.
Исследование показало, что при выращивании T. hamatum совместно с S. sclerotiorum взаимодействие приводило к резкому увеличению образования ЛОС, достигая пика через 17 дней. Некоторые из выявленных химических веществ, включая 1-октен-3-он, оказались способны подавлять не только S. sclerotiorum, но и другие вредоносные грибы, такие как Botrytis cinerea (серая гниль), Pyrenopeziza brassicae (светлая пятнистость листьев) и Gaeumannomyces tritici (заболевание пшеницы).
Результаты исследования показывают, что подобные природные соединения могут стать более устойчивой альтернативой традиционным фунгицидам, которые подвергаются все более жестким нормативным ограничениям в Великобритании и Европе.
Доктор Йозеф Вутс из Ротамстеда, соавтор исследования, отметил: «Необходимы дальнейшие исследования, чтобы понять, как эти грибные ЛОС действуют в реальных условиях сельского хозяйства и можно ли эффективно использовать их в больших масштабах. Однако это открытие вселяет новую надежду на более экологичную защиту растений в условиях, когда сельское хозяйство находится под давлением необходимости сокращать использование химикатов».
Источник: Rothamsted Research.


